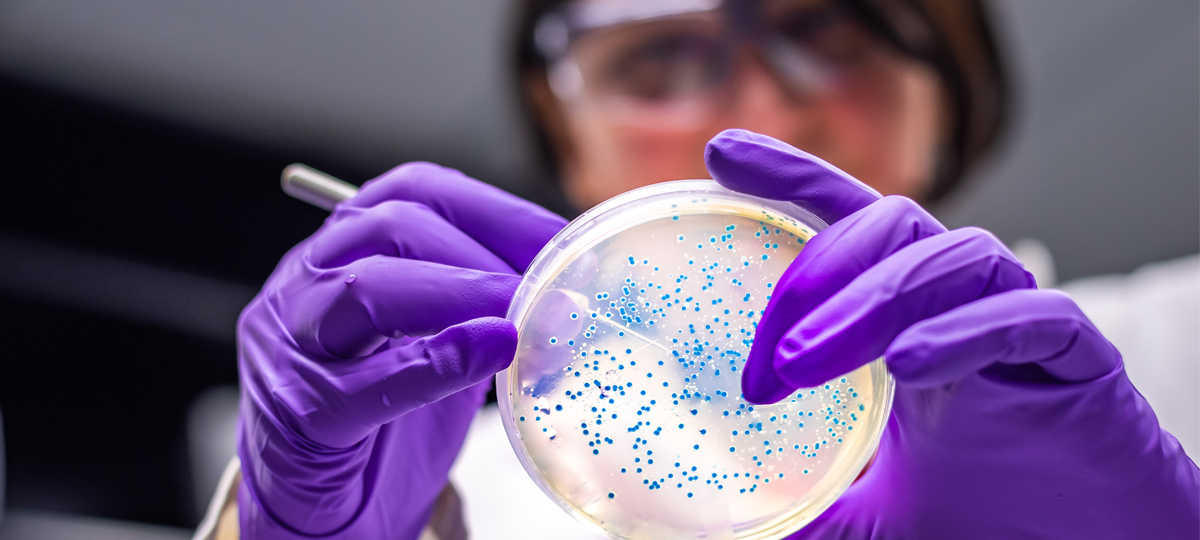

Mohácsiné Farkas Csilla
Élelmiszermérnök, a Budapesti Corvinus Egyetem Élelmiszertudományi Karának kutatásért felelős dékánhelyettese, a Mikrobiológiai és Biotechnológiai Tanszék egyetemi docense
Vegyészmérnök szülők gyerekeként már egész fiatalon a kémia érdekelte, azt gondolta, hogy ő is vegyészmérnök lesz. Kémia tagozatos gimnáziumba járt és nyaranta gyakran dolgozott különböző kémiával kapcsolatos feladatokon. A fizika iránti érdeklődés hiánya miatt végül nem a Műszaki Egyetemre jelentkezet, hanem a Kertészeti Egyetemre (később Kertészeti és Élelmiszeripari Egyetem) élelmiszermérnöki képzésre, ezen belül is a specialitása a mikrobiológia.
A mikrobiológián belül, egy nagyon különleges része a biológiának, az élelmiszerrel kapcsolatos biológia.
Az élelmiszereknél a tartósítás azon alapul, hogy a mikroorganizmusokkal mit tudunk kezdeni, ha a mikroorganizmusok megjelenek akkor vagy megbetegedést, vagy romlást okoznak vagy vannak fermentált élelmiszerek, mint például a joghurt. Remek professzorok és kutatások révén végül ebbe az irányba mozdult el és tanít azóta is az egyetemen. Ez nem egy olyan szakma, ahol az ember meggazdagodik, de az egyik legfontosabb dolognak tartja a világon, amit manapság az újságok, televíziók is hirdetnek, miszerint mennyire fontos a helyes táplálkozás és azon belül is az élelmiszerek minősége, nem szabad, hogy élelmiszerek olyan mikróbákat hordozzanak, amik megbetegedést okoznak. Mást sem hallunk, csak, hogy mennyi különféle járvány sújtja most az emberiséget. Most a Covidtól zeng minden, de az élelmiszerek is közvetítenek akár halálos kimenetelű járványokat és az élelmiszeriparnak és a hatóságnak is az a legnehezebb feladata, hogy ezeket meggátolja. Az élelmiszeripar, és az élelmiszerek technológiája is mind azon alapul, hogy mit tudnak kezdeni ezekkel a mikróbákkal.
 A Campylobacter jejuni baktérium gyakori oka az ételmérgezésnek. A fertőződés baromfi, hús és tejtermékekben alakulhat ki.
A Campylobacter jejuni baktérium gyakori oka az ételmérgezésnek. A fertőződés baromfi, hús és tejtermékekben alakulhat ki.
Korábban kutatóintézetben (Konzervipari Kutatóintézet) is dolgozott, amit nagyon szeretett, ezek a kutatások ma már megszűntek, de pl., ha egy konzervgyárban valami probléma lépett fel (mitől romlik el egy konzerv), akkor arra nekik kellett megoldást találniuk
Borzasztóan tetszett, mert olyanok voltunk, mintha nyomozók lennénk, mentünk az üzembe és megpróbáltuk feltárni, hogy hol van hiányosság és hol lehet egy olyan gyenge pont, ahol a mikróbák szaporodnak és nem lenne nekik szabad.
Jelenleg az egyetemen tanszékvezető tanár, ahol lehetősége nyílik a tanítás mellett kutatni is. Nagyon sok szakirodalmat olvas, hogy a legfrissebb kutatási eredményekkel tisztában legyen, mert egy kutatónak tudnia kell, hogy mások mit csinálnak és hol tartanak bizonyos kérdésekben. Szívesebben töltene egy kicsit több időt a laboratóriumban, de így is néhány óra oktatás után azért a napjai felét a laboratóriumban tölti el; kisérleteket tervez, mindig vannak olyan projektek, amivel szívesen foglalkozik. Kutatási területe közé tartoznak: élelmiszer mikrobiológia; baktériumok hőpusztulása; élelmiszerbiztonság; gyors mikrobiológiai vizsgálati módszerek; új, nem termikus tartósítási technológiák mikrobiológiai megalapozása.
Mikrobiológia
A mikrobiológia a biológiának egy a mikroorganizmusokkal foglalkozó tudományága. Mikrobának nevezünk minden olyan élőlényt, amely nem jutott el a szövetes differenciálódásig, és életciklusának jelentős részében szabad szemmel nem látható. (Régebbi definíció: minden olyan élőlény, amely nem látható szabad szemmel.)
Három nagy szakterületet foglal magába: a virológiát, bakteriológiát és az immunológiát.
A mikrobiológiában az a legérdekesebb, hogy akkora élőlényekkel foglalkozunk, akiket nem lehet szabad szemmel látni. Úgy kell tudni a tulajdonságaikat megismerni, hogy közben nem látjuk őket, legfeljebb mikroszkóppal, ami aztán igazán különlegesen izgalmassá teszi a dolgot.
